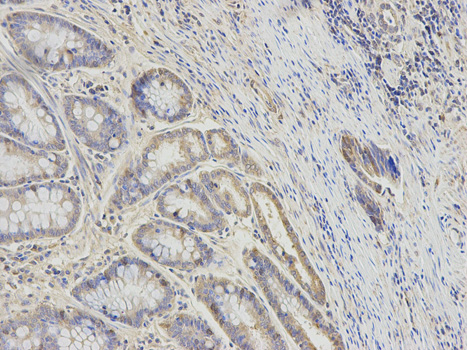

Anti-RRM2 Antibody
A30719
ApplicationsWestern Blot, ImmunoHistoChemistry
Product group Antibodies
ReactivityHuman, Mouse, Rat
Overview
- SupplierAntibodies.com
- Product NameAnti-RRM2 Antibody
- Delivery Days Customer7
- ApplicationsWestern Blot, ImmunoHistoChemistry
- CertificationResearch Use Only
- ClonalityPolyclonal
- ConjugateUnconjugated
- Estimated Purity>95%
- HostRabbit
- Scientific DescriptionRabbit polyclonal antibody to RRM2
- ReactivityHuman, Mouse, Rat
- UNSPSC12352203

![Immunohistochemical analysis of paraffin-embedded zebrafish tissue, using RRM2 antibody [N1C1] (GTX103193) at 1:300 dilution.](https://www.genetex.com/upload/website/prouct_img/normal/GTX103193/GTX103193_40128_IHC_Z_22111423_284.webp)